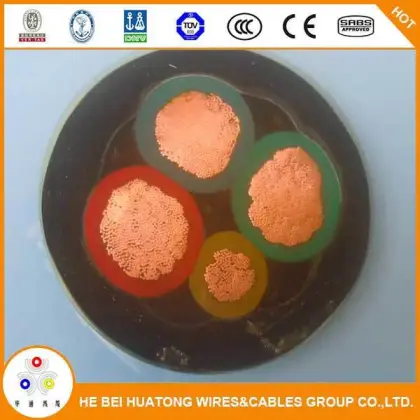
Heavy Duty General Rubber Mining Trailing Cable

General Cable Mining Cables
Brand Introduction
The Advantages Of General Cable Mining Cables:
Known for its high-performance cables, General Cable offers fire-resistant products designed for safety and reliability.
Meter/Meters
Min.order : 1000 Meter/Meters
Min.order : 1000
Piece/Pieces
Min.order : 1 Piece/Pieces
$0.5000
- $
3.0000
meter
Min.order : 1 meter
$980.0000
- $
1000.0000
Kilometer
Meter
Min.order : 10000 Meter
$20.0000
- $
20.0000
Piece/Pieces
Min.order : 20 Piece/Pieces
$300.0000
- $
300.0000
Others
Min.order : 1 Others
Related Brand:
JK Drilling
, zhongjin
, HW Brand
, SINOTAI
, Taihan
, nVent
, Lapp
, Helukabel
, Draka
, Furukawa Electric
Related Industry:
Water pipes
, Floor heating pipes
, Imported water pipes
, PPR tube
, Stainless steel water pipe
, Aluminum plastic pipe
, Explosion-proof pipe
, PVC tube
, Pe tube
, pp tube
, pert tube
, Wire threading tube
, hdpe drain pipe
, Stainless steel pipe fittings
, hose
, Heat shrink tube
, Gas pipe
, Wire skeleton composite tube
, Flexible waterproof casing
, Tee
, Same-level drainage
, Siphon drainage
, Floor heating water distributor
, Electric floor heating
, Graphene floor heating
, Integrated wiring
, Network cable
, Crystal head
, Wires and cables
, Home decoration wires
, Armored cable
, High voltage cable
, Aluminum alloy cable
, Imported cables
, Sliding touch line
, Enameled wire
, Raw material belt
, Electric meter
, Water meter
, Faucet
, Shower
Recommended Related Videos

Please Send Message
${inquiryTitle}